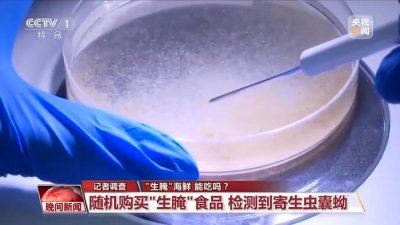
生食海鱼比淡水鱼更安全?专家:误区!有人食用后感染寄生虫!

29条比较搞笑逗比的句子, 发朋友圈很有趣的说说
1..对今天解决不了的事情,也不要着急。因为明天也可能还是解决不了。
2.“跟不喜欢的人在一起什么感觉?”“辣条都不想分给他半根”。
3.别看我平时对你漠不关心,其实背后有说你好多坏话的。

4.谈恋爱应该处处让着男朋友,让他做饭,让他洗碗,让他洗衣,让他赚钱,女生呢就辛苦一点,负责吃,负责喝,负责买买买。
5.怎么形容自己的厨艺,烧得一手好厨房,说起来你可能还不信,是锅先动的手。
6..脑子是个好东西,但如果你胸大,没有也行。

7.如果你长期找不到对象,那就要反思一下,是不是自己对性别的要求太高了?
8.明人不说暗话,这羊肉串多少钱。
9.坚持不见得成功,可是放弃却会很轻松。

10.我本以为我们可以一起走到最后,可没想到走了几步你就开始打车了。
11.你特别像个小孩子你知道吗?我不是说你幼稚,更没说你可爱,我只是说你特别像我儿子。
12.每天早点睡,没事少玩点手机,对手机不好。

13.谁说我不会乐器?我退堂鼓打的可好了。
14.看了网上有很多说熬夜的坏处,这些对我最大的改变就是从开开心心的熬夜变成了提心吊胆的熬夜。
15.世界上本来是没路的,乱走的人多了,搞得我不知道怎么走了。

16.一生败在太要脸,爱钱爱得不明显。
17.人还是要多出去走走,不然根本不知道在家里玩手机有多舒服。
18.三分忙,七分瞎忙,总算把这生活凑满了十分。

19.我一在强调做人要低调,可你们非要给我掌声和尖叫。
20.你走了真好,不然总担心,你要留下来吃饭。
21.好不容易习惯了自己的长相,理了个发,又换了一种丑法。

22.我就是不讲道理,因为我是以有趣服人的。
23.希望大家理智的追星,不要为我熬坏了身体。
24.你无法叫醒一个不回你信息的人,但是红包能!

25.当时年纪小,喜欢装文艺,现在病好了,只喜欢钱。
26.秀恩爱的人换了一批又一批,只有我,雷打不动地单身。
27.昨天我写了两分钟作业,然后手机就生气了,我足足哄了它两个小时,我能怎么办,我也很无奈啊。
28.你的意中人是个盖世猴子,有一天他会两段位移,越塔大招来娶你的狗命。
29.放假以后,同桌就没有了音讯,我的感觉就像丢了我家猪一样。痛苦!